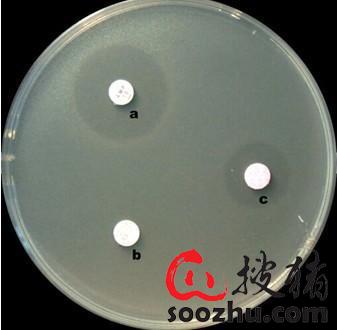
201909221100205299.jpg

“抗生素”,是指由微生物(包括细菌、真菌、放线菌属)或高等动植物在生活过程中所产生的具有抗病原体或其他活性的一类次级代谢产物,能干扰其他生活细胞发育功能的化学物质。现临床常用的抗生素有微生物培养液中的提取物以及用化学方法合成或半合成的化合物。
目前养猪临床上抗生素有两种用法:一种是被饲料厂直接添加到饲料中作为饲料添加剂使用,发挥其防病以及促生长作用;一种是被养猪人自行通过饮水、拌料或者肌注等给药方式给动物给药,发挥抗生素防病治病的作用。

抗生素虽然在猪病的预防和控制上功不可没,对人兽共患病的防控也发挥着不可忽视的作用,但抗生素在临床应用上是把“双刃剑”,正确使用抗生素可以充分发挥抗生素的功能,降低发病率,提高生猪生长速度。若抗生素使用不规范就会出现各种问题:
(1)药物残留、食品安全问题
随着人们生活水平的提高,人们对食品安全问题也是越来越重视,这一点可从人们对绿色蔬菜、土猪肉的青睐中反映出来。任何一种抗生素都有休药期,若是不遵守休药期而是随意使用,就会导致猪肉中存在抗生素残留,影响食品安全。

(2)猪群健康问题
抗生素进入猪群体内,在杀灭猪群体内有害细菌的同时,也会杀死有益细菌。研究发现长时间使用抗生素会导致猪群体内有益菌群混乱,影响消化系统和生殖系统的正常功能,进而导致母猪便秘以及子宫内膜炎的发病率升高。

还有一些抗生素存在比较严重的毒性,比如养猪常用的氟苯尼考就具有免疫抑制作用及可逆性的红细胞生成抑制,此外还具有胚胎毒性,影响胎儿的发育和哺乳期间的生长。磺胺类药物具有明显的肾毒性,长时间大剂量使用磺胺类药物,会在猪群肾脏中形成结晶,影响肾脏功能。
(3)诱导耐药菌的产生
下表为1997年和2012年,临床上分离的大肠杆菌K88株耐药数据统计,可以发现在1997年该毒株对多数抗生素都敏感,而到了2012年该毒株获得了多数抗生素的耐药性,其中耐药性比较严重的就包括临床常用的强力霉素、磺胺类药物、土霉素及氟苯尼考,即使是头孢噻呋都无法保证100%敏感。像临床上常见的副猪嗜血杆菌、链球菌、传染性胸膜肺炎放线杆菌、巴氏杆菌等都存在同样的问题。

养猪临床上如何正确使用抗生素
抗生素不是万能的,但是没有抗生素也是不行的,要想让抗生素长时间为养猪人服务,就需要我们学会正确使用抗生素。
(1)改善硬件设施,减少抗生素用量
很多养猪朋友养猪进入了一个误区,将疾病防控的重任完全压在了抗生素身上,而忽视了硬件设施对养猪的影响。可实际上通过改善硬件实施的方式进行疾病防控,不仅节省了药物使用成本,而且防病效果更好。比如通过提高猪舍内的温度、降低湿度,就可降低产房仔猪腹泻的发病率,也可降低保育仔猪副猪嗜血杆菌等条件致病菌的发病率。通过改善猪舍内的通风条件,可以降低猪群各种呼吸道疾病的发病率。

(2)定期进行药物敏感性检测
随着抗生素使用时间的延长,细菌就会逐渐对其产生耐药性,导致抗生素使用效果变差,甚至无效。而使用无效的抗生素进行疾病的防治,还会诱导其它细菌产生耐药性。猪场定期进行药物敏感性检测,筛选敏感抗生素,用药时选择敏感药物,才能达到更好的防病治病效果。
(3)纠正预防减半的错误观念
前几年一些抗生素厂家为了突出自家药物的特点,会推荐养猪朋友在预防疾病时减半,而实际上很多抗生素属于浓度依赖性药物,猪群体内药物浓度达不到就起不到良好的杀菌、抑菌效果,细菌无法及时杀死反而会诱导细菌更快速得产生耐药性。
正确的做法是根据抗生素分类采取不同的给药方式,比如β-内酰胺类(青霉素)、大环内酯类(替米考星、泰乐菌素)就属于时间依赖性药物,要想达到最佳的使用效果,就需要持续给药。而氨基糖苷类(庆大霉素、新霉素)、奎喏酮类(恩诺沙星、环丙沙星)等属于浓度依赖性药物,就需要一次给足药物才能达到良好的使用效果,若是按照预防减半的方法给药,就根本起不到效果。

(审核编辑: 猪猪侠)





















